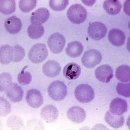
스펙트라 이미지

스펙트라 - 영등포구 총65명이 열람하였으며, 0개의 리뷰가 있습니다.
- 번호
- 33,943
- 개방서비스명
- 의료기기판매(임대)업
- 개방서비스아이디
- 01_02_03_P
- 개방자치단체코드
- 3,180,000
- 관리번호
- PHMG120223180034047000434
- 인허가일자
- 2021-03-24
- 영업상태구분코드
- 1
- 영업상태명
- 영업/정상
- 상세영업상태코드
- 13
- 상세영업상태명
- 영업중
- 소재지전체주소
- 서울특별시 영등포구 영등포동*가 **-** 남양빌딩
- 도로명전체주소
- 서울특별시 영등포구 양산로 ***, 남양빌딩 *층 ***호 (영등포동*가)
- 도로명우편번호
- 7,245
- 사업장명
- 스펙트라
- 최종수정시점
- 2023-01-03 16:44:00
- 데이터갱신구분
- U
- 데이터갱신일자
- 2023-01-05 02:40:00
- 좌표정보x(epsg5174)
- 127
- 좌표정보y(epsg5174)
- 38
- 총규모
- 39
- 전화번호
- 063-278-8183
주변 목록
더엣지
서울특별시 영등포구 영등포동*가 **번지 **호 남영빌딩
'스펙트라'에서 0km
서울특별시 영등포구 영등포동*가 **번지 **호 남영빌딩
바로가기
영등포 수면양압기센터
서울특별시 영등포구 영등포동*가 **번지 **호 남양빌딩
'스펙트라'에서 0km
서울특별시 영등포구 영등포동*가 **번지 **호 남양빌딩
바로가기
(주)미래이씨피 지점
서울특별시 영등포구 영등포동*가 **
'스펙트라'에서 0.1km
서울특별시 영등포구 영등포동*가 **
바로가기
바이오에스테
서울특별시 영등포구 영등포동*가 **
'스펙트라'에서 0.1km
서울특별시 영등포구 영등포동*가 **
바로가기
아진의료기
서울특별시 영등포구 영등포동*가 **번지
'스펙트라'에서 0.1km
서울특별시 영등포구 영등포동*가 **번지
바로가기
로얄상사(Royal Company)
서울특별시 영등포구 영등포동*가 **번지
'스펙트라'에서 0.1km
서울특별시 영등포구 영등포동*가 **번지
바로가기
지에스25 영등포시장역점
서울특별시 영등포구 영등포동*가 **
'스펙트라'에서 0.1km
서울특별시 영등포구 영등포동*가 **
바로가기
자수정출판
서울특별시 영등포구 영등포동*가 **번지
'스펙트라'에서 0.1km
서울특별시 영등포구 영등포동*가 **번지
바로가기
주변 의료기기 수리업
(주)디오메드
서울특별시 영등포구 영등포동5가 114번지
'스펙트라'에서 0.21km
바로가기
헬스드림
서울특별시 영등포구 영등포동4가 146-1
'스펙트라'에서 0.35km
바로가기
(주)세신유나이티드
서울특별시 영등포구 당산동1가 459 생각공장 당산
'스펙트라'에서 0.63km
바로가기
신우메디랜드(주)
서울특별시 영등포구 당산동 121번지 150호 대한결핵협회 1층
'스펙트라'에서 0.66km
바로가기
마레헬스케어
서울특별시 영등포구 문래동3가 55-16 영등포 SK 리더스뷰
'스펙트라'에서 0.72km
바로가기
에이원의료기
서울특별시 영등포구 문래동3가 96번지 103호
'스펙트라'에서 0.75km
바로가기
(주)아게이트 복음보청기 영등포점
'스펙트라'에서 0.79km
바로가기
스타키보청기 영등포센터
서울특별시 영등포구 영등포동 618번지 91호
'스펙트라'에서 0.79km
바로가기
(주)수도헬스케어
'스펙트라'에서 0.92km
바로가기
(주)재명산업
서울특별시 영등포구 영등포본동 618번지 161호 5층
'스펙트라'에서 0.94km
바로가기
(주)하이덴탈코리아
서울특별시 영등포구 문래동3가 55번지 20호 에이스하이테크시티 2동 207호
'스펙트라'에서 1.04km
바로가기
(주)비전바이오솔루션
서울특별시 영등포구 당산동4가 80 당산 SK V1 center W동 122비호
'스펙트라'에서 1.04km
바로가기
주변 부속 의료기관
영등포보현의집 부속의원
서울특별시 영등포구 영등포동2가 94번지 31호 1층
'스펙트라'에서 0.73km
바로가기
국회사무처부속의원
서울특별시 영등포구 여의도동 1번지
'스펙트라'에서 1.31km
바로가기
국회사무처부속한의원
서울특별시 영등포구 여의도동 1 국회
'스펙트라'에서 1.31km
바로가기
국회사무처부속치과의원
'스펙트라'에서 1.31km
바로가기
금융감독원부속치과의원
'스펙트라'에서 1.47km
바로가기
한국산업은행부속치과의원
서울특별시 영등포구 여의도동 16번지 8층
'스펙트라'에서 1.63km
바로가기
한국수출입은행부속치과의원
서울특별시 영등포구 여의도동 16번지 1호
'스펙트라'에서 1.77km
바로가기
국민은행 본점 부속의원
서울특별시 영등포구 여의도동 45 KB국민은행 신관
'스펙트라'에서 2.04km
바로가기
엘지에너지솔루션부속의원
서울특별시 영등포구 여의도동 22 파크원
'스펙트라'에서 2.11km
바로가기
엘지트윈부속의원
서울특별시 영등포구 여의도동 20
'스펙트라'에서 2.24km
바로가기
병무청중앙신체검사소
서울특별시 영등포구 신길동 산 159번지 1호
'스펙트라'에서 2.32km
바로가기
서울지방병무청
서울특별시 영등포구 신길동 산 159번지 1호
'스펙트라'에서 2.32km
바로가기
주변 의료 유사업
스마일안마원
서울특별시 영등포구 영등포동3가 20-6
'스펙트라'에서 0.64km
바로가기
건강플러스지압안마원
서울특별시 영등포구 당산동3가 270번지 우미빌딩 121호
'스펙트라'에서 0.73km
바로가기
드림안마시술소
서울특별시 영등포구 영등포동 423번지 44호
'스펙트라'에서 0.81km
바로가기
평강안마원
서울특별시 구로구 구로동 26번지 신도림포스빌 401호
'스펙트라'에서 2.24km
바로가기
씨에프(CF)안마시술소
서울특별시 영등포구 여의도동 44번지 32호 4,5층
'스펙트라'에서 2.27km
바로가기
참손길지압안마원
서울특별시 영등포구 여의도동 44-37 아일렉스타워
'스펙트라'에서 2.34km
바로가기
손박사지압안마원
서울특별시 영등포구 신길동 832번지
'스펙트라'에서 2.54km
바로가기
목동건강안마원
서울특별시 양천구 목동 405번지 216호
'스펙트라'에서 2.77km
바로가기
참손길안마원
서울특별시 마포구 합정동 372번지 28호
'스펙트라'에서 2.84km
바로가기
힐링지압안마원
서울특별시 동작구 대방동 417번지 2호 3층
'스펙트라'에서 3.01km
바로가기
맑은손안마원
서울특별시 마포구 합정동 386번지 39호
'스펙트라'에서 3.12km
바로가기
동작약손지압안마원
서울특별시 동작구 노량진동 41번지 5호 307호
'스펙트라'에서 3.14km
바로가기
주변 의료법인
의료법인 건양의료재단
서울특별시 영등포구 영등포동4가 123번지 2호
'스펙트라'에서 0.47km
바로가기
의료법인 창덕의료재단
서울특별시 영등포구 당산동2가 4번지 3호
'스펙트라'에서 0.86km
바로가기
의료법인 인봉의료재단
서울특별시 영등포구 당산동3가 386번지 3호 영등포병원
'스펙트라'에서 0.89km
바로가기
성애의료재단
서울특별시 영등포구 신길동 451번지 2호 성애병원
'스펙트라'에서 2.01km
바로가기
의료법인 마티아의료재단
서울특별시 영등포구 대림동 603번지 26호 코스모메디칼
'스펙트라'에서 2.08km
바로가기
해인의료재단
서울특별시 양천구 목1동 404번지 256호
'스펙트라'에서 2.47km
바로가기
의료법인 춘혜의료재단
서울특별시 영등포구 대림3동 782번지 3호
'스펙트라'에서 2.57km
바로가기
의료법인 서울효천의료재단
서울특별시 관악구 신림동 10-715 양지병원
'스펙트라'에서 2.58km
바로가기
의료법인 우리아이들 의료재단
서울특별시 구로구 구로동 586번지 5호
'스펙트라'에서 3.03km
바로가기
의료법인 성석의료재단
서울특별시 동작구 상도동 188번지 19호
'스펙트라'에서 3.57km
바로가기
학교법인고려중앙학원
서울특별시 구로구 구로동 80번지
'스펙트라'에서 3.85km
바로가기
에이치엠피의료재단
서울특별시 동작구 신대방동 686번지 1호
'스펙트라'에서 3.85km
바로가기
주변 병원
새길병원
'스펙트라'에서 0.14km
바로가기
신화요양병원
'스펙트라'에서 0.27km
바로가기
덕수의료재단 서울브레인병원
서울특별시 영등포구 영등포동4가 153번지 1호
'스펙트라'에서 0.41km
바로가기
경희우리한방병원
서울특별시 영등포구 영등포동3가 7 영등포 점프밀라노
'스펙트라'에서 0.44km
바로가기
건양의료재단 김안과병원
서울특별시 영등포구 영등포동4가 156번지
'스펙트라'에서 0.45km
바로가기
한림대학교 한강성심병원
'스펙트라'에서 0.45km
바로가기
씨엠병원
'스펙트라'에서 0.46km
바로가기
마리아성모요양병원
'스펙트라'에서 0.48km
바로가기
신세계서울병원
'스펙트라'에서 0.72km
바로가기
의료법인 인봉의료재단 영등포병원
'스펙트라'에서 0.89km
바로가기
서울센트럴요양병원
'스펙트라'에서 1.14km
바로가기
한강수병원
'스펙트라'에서 1.22km
바로가기
블로그 리뷰
-
진드기나 심장사상충 걱정을 안 할 수가 없더라고요. 그래서 오늘은 우리 아이들을 위해 준비한 내외부 기생충 + 심장사상충 예방약, 넥스가드 스펙트라 내돈내산 후기를 들려드리려고 합니다! 🏥 병원 대신 선택한 이유 원래는 매달 동물병원에 가서 바르는 약으로 관리해 줬어요. 근데 매번 시간 맞춰 방문하는 게...
sue_archive(2026-04-10 15:18:00)

-
대여 베이비봄날(스펙트라 안양의왕대리점) 유축기 대여를 했다:) 스펙트라 유축기 대여후기 6월 4째주 주간일기 오늘은 두 달 동안 대여했던 #스펙트라유축기 를 반납했다 스펙트라 안양의왕대리점에... m.blog.naver.com 4년 전에도 베이비봄날에서 유축기 2달 대여했었는데 둘째 출산 후 또 대여했다는..ㅎ.ㅎ...
소소한 블로그:D(2026-02-17 23:04:00)

-
미리 예방해두는 게 중요합니다. 👉 그래서 요즘은 강아지 심장사상충과 진드기 예방을 같이 고민하시는 분들이 많아요. 💊 넥스가드 스펙트라 효과 (2026 기준) 넥스가드 스펙트라 후기를 찾아보면 👉 한 번으로 내·외부 기생충을 함께 예방할 수 있다는 점이 가장 큰 장점이에요. ✔ 예방 범위 심장사상충 회충 / 편충...
애개육아_소소한일상❤(2026-04-19 10:51:00)

-
수 있으므로 이상 반응이 보이면 동물 병원 상담이 필요해요. 또 처음 급여하기 전에는 심장 사상충 검사 후 급여하는 것이 권장돼요. 강아지 넥스가드 스펙트라 후기 정리 지금까지 세리가 실제로 급여하고 있는 넥스가드 스펙트라에 대해 정리해 볼게요. 체크포인트 ✔ 내부 기생충과 외부 기생충을 한 번에 관리...
엘리하우스(2026-03-14 10:00:00)

-
기생충 등으로부터 보호하세요 강아지용 고양이용 17,633 후기들 ... 그리고 더 4.97 모든 후기를 읽어보기 이제 여러분의 반려동물을 최고의 건강 상태로 유지...및 진드기, 벼룩 치료제들을 제공... www.petbucket23.com 넥스가드 스펙트라 스몰 (Nexgard Spectra Small) 3.5 - 7.5 kg 강아지용 - 6개입 홈 » 강아지...
콩작소일 (콩누나의 작고 소소할 일상)(2026-03-26 13:03:00)

-
있다!!! 별거 아니지만 새벽에 유축할 때 진짜 유용함,,,, 수유할 때도 수유등으로 사용했더니 아주 편했다🫶🏻 * 메델라 심포니가 스펙트라보다 부드럽고 압이 약해서 좋다는 후기가 많은데….. 아무래도 강철꼭지쓰인지….^^ 둘 다 안 아파서 기능이 더 많은 스펙트라가 좋았다 (물론 락티나는 조금 아팠다…) 모닝...
Buen viaje!(2026-04-06 11:50:00)

-
다녀온 후기 남겨볼게요 신탄제일큰약국 대전광역시 대덕구 신탄진로 824 1층 신탄제일큰약국 대전 대덕구 신탄진로 824, 1층 월화수금토 10:00~20:00 일 10:00~18:00 매주 목요일 정기휴무 약국 뒤 전용주차장 무료(30분 제공) 대전사랑카드 사용가능 신탄제일큰약국에 방문했답니다 대전창고형약국답게 큰 건물에...
RAMOON(۶•̀ᴗ•́)۶(2026-03-27 16:10:00)

-
관리방법 유축기 관리법은 내장된 설명서 첨부 했다 요약하자면 모유가 닿는 기구들만 열탕 소독 1분내외 하면된다 사용후기 결론적으로 스펙트라 Q플러스 후기는 구매후기 잘 뒤져보지도 못하고 급하게 구매하게 되었는데 아주아주 만족하는 제품이다 성능이 좋아 사는 순간 뽕뽑는 수준이랄까..? 꼭지랑...
두렵지 않은 퓨잉(2026-03-20 20:30:00)

-
낳아서 준비된 게 하나도 없을 시기였어요. 감사하게도 이른둥이를 낳은 가정을 위해 이런저런 지원을 해주는 기업이 몇 군데 있었어요. 1. 유축기 대여: 스펙트라 2. 이른둥이 기저귀 150장: 하기스 3. 50ml 모유저장팩 500개: 마더케이 4. 이른둥이 유리젖병 100ml: 더블하트 2025년 말 기준 흥하십쇼. 진짜. 저는 네...
푸르뎅뎅의 노트(2026-03-14 17:52:00)

-
시기에는 매번 열탕을 하지 않아도 돼서 좋았어요! 산후조리원에서까지 정말 필요할까 고민하다가 산후조리원에서 직접 사용해 보고 선택한 제품은 !! 스펙트라 젖병소독기 김천공공산후조리원의 자세한 후기는 아래 링크에서 확인해 주세요!! https://m.blog.naver.com/tngml9144/224198595416 김천공공산후조리원...
ʚ 일상 기록 ɞ(2026-03-03 15:03:00)

일별 방문 통계
월별 방문 통계
날씨
리뷰 (0)
등록된 리뷰가 없습니다.
첨부파일

![스펙트라 | [내돈내산] 심장사상충과 내외부기생충을 한 번에!🐶 넥스가드 스펙트라 급여 후기](https://search2.kakaocdn.net/argon/130x130_85_c/5U0nGtoD6kx)


![스펙트라 | [내돈내산] 강아지 넥스가드 스펙트라 후기|심장사상충·벼룩·진드기 한 번에 예방하는 구충제](https://search3.kakaocdn.net/argon/130x130_85_c/9T3uEOYD6YF)




![스펙트라 | 감사해서 쓰는 이른둥이 유축기 지원] 스펙트라 유축기 대여 후기](https://search4.kakaocdn.net/argon/130x130_85_c/DA6yi9CnZoP)
